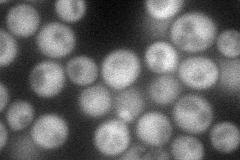
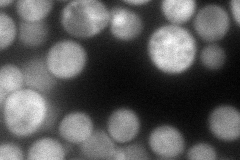
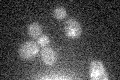

View description
Similar to 6-phosphofructo-2-kinase/fructose-2,6-bisphosphatase enzymes responsible for the metabolism of fructoso-2,6-bisphosphate; mRNA expression is repressed by the Rfx1p-Tup1p-Ssn6p repressor complex; YLR345W is not an essential gene
Localization:
Intensity:
Fold change:
Significance:
-
C’ GFP library in SD

below threshold15.86 -
N' NOP1pr-GFP in SD
cytosol80.0256 -
N' TEF2pr-mCherry in SD
cytosol95.4492 -
N' NATIVEpr-GFP in SD

cytosol33.8599 -
N' TEF2pr-VC and Cyto-VN in SD

cytosol42.7403 -
C’ GFP library in SD+DTT

cytosolN/AN/ANo -
C’ GFP library in SD+H2O2

cytosolN/AN/ANo -
C’ GFP library in Starvation Media
cytosolN/AN/AYes -
C’ GFP library on the background of Pup2-DaMP

below threshold -
C’ GFP library on the background of CCT mutant

below thresholdN/AN/ANo
